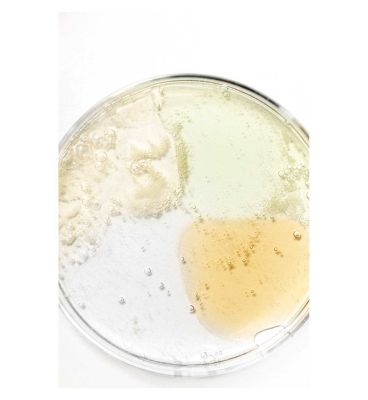

Brandlistry is Africa’s premier health & beauty marketplace, connecting customers to authentic beauty, skincare, wellness, and personal care products from trusted brands.
Yes. We partner directly with verified brands and trusted vendors. Every product goes through a strict vetting process before being listed.
Simply browse our marketplace, add items to your cart, and proceed to checkout. You can pay securely online using our supported payment methods.
Yes, we do. Please send your customisation requests to email@domain.com, we will give you our quote. Thank you.
Normally we don't provide support during weekends, except for urgent cases. In these cases, you only need to mark “Urgent” in your email, we will get back to you ASAP.
1/ Create a staff account for us (with Themes permission and Settings permission) http://docs.shopify.com/manual/settings/account/staff-members
2/ Capture screenshot or video for the issue you get.
3/ Specify which template and version you are using.
4/ Describe clearly how to reproduce the issue.
5/ Submit a support ticket at here: https://halosoft.ticksy.com/. Our support team will get back to you soonest, please help us to wait.